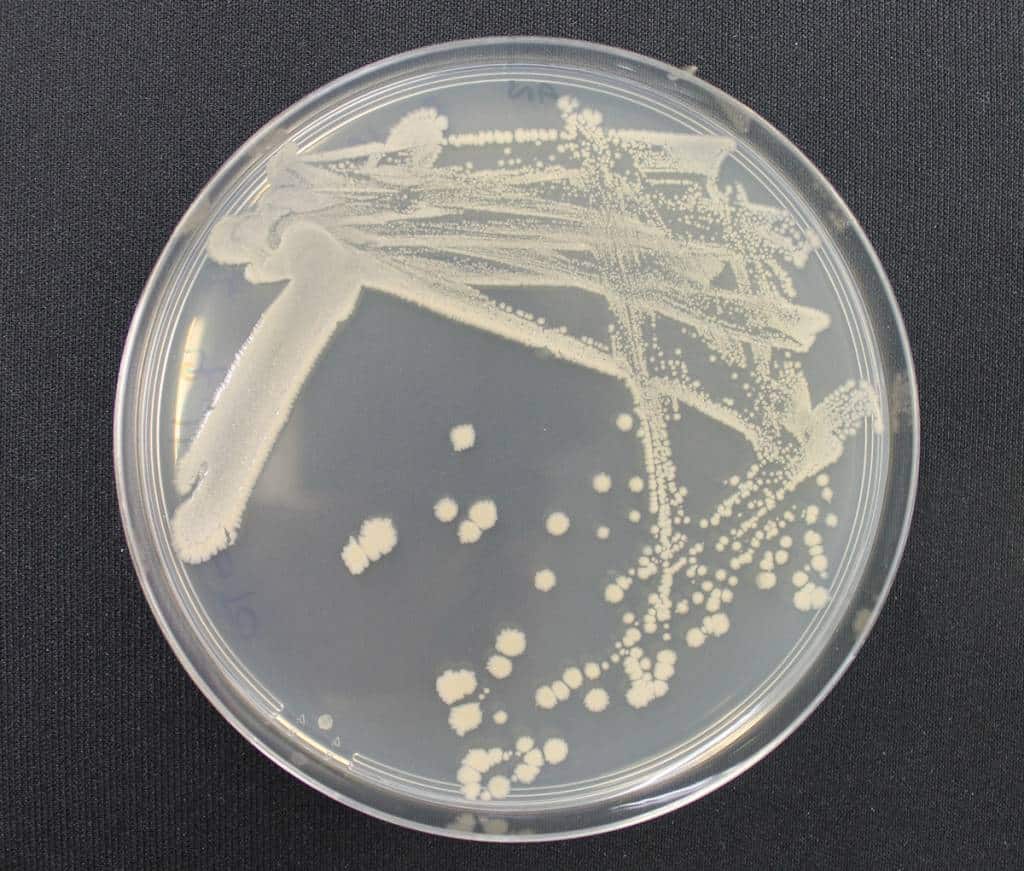

Esta innovación aprovecha la potente actividad nematicida de la cepa B410 de Metabacillus halosaccharovorans, presentando una solución ecológica para combatir nematodos y proteger el rendimiento de los cultivos.
Los estudios preliminares en cámaras de crecimiento, invernaderos y campos muestran una elevada eficacia contra cuatro especies del género Meloidogyne y dos especies del género Globodera, dos de los grupos más extendidos y económicamente importantes. Con pérdidas anuales globales estimadas en 157.000 millones de dólares debido a los nematodos, esta tecnología representa un avance significativo en la gestión sostenible de estas plagas.
Futureco Bioscience, empresa biotecnológica española especializada en la investigación, desarrollo y fabricación de productos biológicos, ha obtenido de la Oficina Europea de Patentes una nueva patente (EP 3934428 B1) para una nueva tecnología de bionematicidas microbianos. Este logro subraya la inversión de Futureco Bioscience en investigación e innovación y resalta el papel crucial de la empresa en el avance de la industria de fabricación de biocontrol.
La patente reconoce la cepa innovadora B410 de Metabacillus halosaccharovorans, aislada de un suelo de agricultura ecológica en Almería (España). Esta cepa posee propiedades nematicidas y se distingue por sus características mesófilas, neutrófilas y halotolerantes, así como por su notable capacidad para producir biopelículas. Estas cualidades la hacen especialmente valiosa para la agricultura en regiones áridas y ambientes salinos.
Aunque los estudios están en curso, los resultados preliminares han demostrado que esta cepa inhibe notablemente la eclosión de huevos de nematodos. Su eficacia es particularmente evidente contra los nematodos del nudo de la raíz (RKN) Meloidogyne incognita, M. javanica, M. arenaria y M. hapla, así como contra los nematodos del quiste de la patata (PCN) Globodera rostochiensis y Globodera pallida.
La primera formulación del ingrediente activo se ha diseñado como una dispersión oleosa (DO), que garantiza una dispersión altamente estable del ingrediente activo en un disolvente inmiscible en agua. Esta formulación se ha logrado mediante un enfoque de fabricación escalable, utilizando tecnología de fermentación líquida de última generación. Este proceso está diseñado para mantener una alta concentración del microorganismo activo, alcanzando niveles del orden de 10^9 UFC/mL.
Carolina Fernández, directora de I+D de Futureco Bioscience, comenta: «Actualmente, no existen productos nematicidas realmente eficaces, ya sean biológicos o químicos, que puedan abordar adecuadamente los problemas del sector. Esto se debe principalmente al complejo ecosistema del suelo donde prosperan estas plagas. El binomio nematodo-nematicida y la eficacia del tratamiento nematicida están influidos por las complejas características del suelo (tipo, textura, estructura, aireación, contenido de humedad, pH, etc.) y el microbioma presente. Además, cada ecosistema tiene poblaciones y especies únicas, y la eficacia de un nematicida puede variar según las condiciones de campo y geográficas«. Fernández continúa: «Es crucial probar la actividad nematicida potencial de un microorganismo en una amplia gama de condiciones in vitro, y luego en cámaras climáticas e invernaderos antes de los ensayos de campo. En determinados escenarios, esperamos que la eficacia se vea comprometida hasta cierto punto. Afortunadamente, en Futureco Bioscience, nuestras instalaciones nos permiten replicar y probar una amplia variedad de escenarios, lo que nos permite ofrecer resultados sólidos y fiables al campo«.

El doble impacto de los nematodos: los saboteadores ocultos de la agricultura
Se estima que las pérdidas anuales a nivel mundial debidas a los nematodos alcanzan aproximadamente los 157.000 millones de dólares, lo que representa el 12% de la producción agrícola global. Estas pérdidas se deben a los daños directos en los cultivos, la disminución de los rendimientos y el aumento de los costos de producción. Además de afectar a los cultivos, las infestaciones de nematodos pueden incrementar los costos de producción al requerir el uso de estrategias de gestión costosas, como el control químico. Esto puede agravar la carga financiera de los agricultores, especialmente en países en desarrollo con recursos limitados.
Al mismo tiempo, el Informe sobre el mercado mundial de nematicidas 2024 de The Business Research Company proyecta un crecimiento significativo del mercado de nematicidas, que se espera que alcance los 2.310 millones de dólares en 2028, con una tasa de crecimiento anual compuesta (TCAC) del 8,0%. Entre los factores que impulsan este crecimiento se encuentran la expansión de la agricultura ecológica, la agricultura de precisión y el impacto del cambio climático. En este sentido, la fusión de tendencias abarca la certificación de agricultura sostenible, los nematicidas biológicos, la investigación y la innovación, la toma de decisiones basada en datos y los nematicidas químicos.